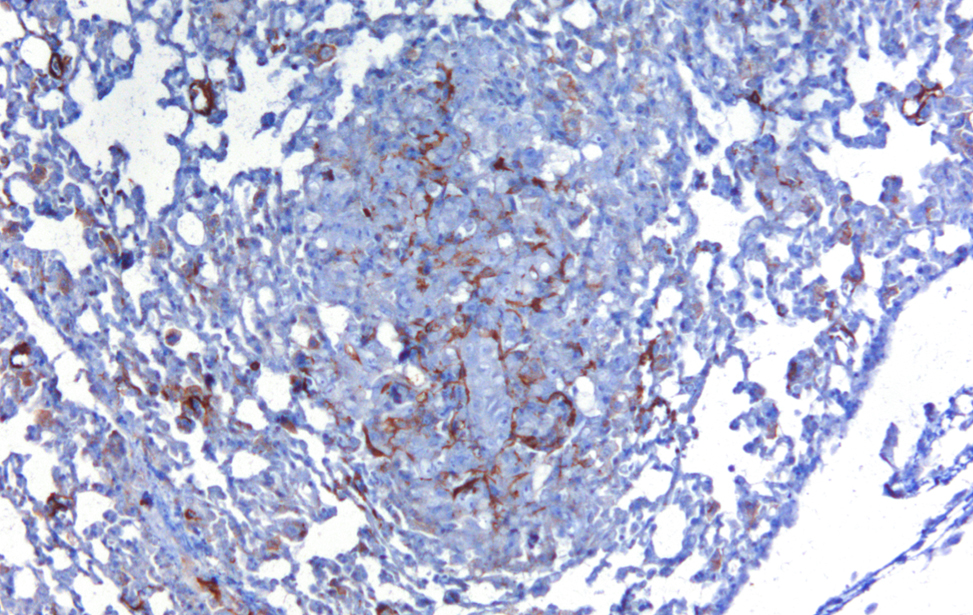

Segnalazione cellulare,
microambiente tumorale e metabolismo
Contesto scientifico
Questo programma di ricerca nasce dalla lunga esperienza di Giannino Del Sal nel campo della biologia del cancro, in particolare nello studio dei meccanismi molecolari che coinvolgono la proteina p53 nella sua forma normale (wild-type) e mutata. La sua attività ha portato a diverse scoperte innovative su questi percorsi biologici.
La p53 è una proteina con funzione di oncosoppressore, ovvero protegge l’organismo dallo sviluppo dei tumori. Regola quasi tutti gli aspetti del comportamento cellulare e rappresenta una barriera fondamentale contro la trasformazione tumorale e la progressione del cancro. Lo fa grazie alla sua straordinaria capacità di raccogliere segnali di stress – come danni al DNA, mancanza di ossigeno, squilibri metabolici – e di attivare una rete complessa di risposte protettive per mantenere l’equilibrio cellulare e la stabilità del genoma.
Le mutazioni missenso del gene TP53 – cioè errori genetici che modificano un singolo amminoacido della proteina – sono tra le alterazioni più frequenti nei tumori umani. Le varianti mutate di p53 associate al cancro (mutp53) non solo perdono la loro funzione protettiva, ma acquisiscono nuove funzioni oncogeniche: diventano cioè attivatori del cancro, promuovendo la crescita del tumore, la sua capacità di diffondersi (metastasi) e la resistenza ai farmaci.
Attraverso un'estesa rete di interazioni con regolatori dell'espressione genica (i fattori di trascrizione), enzimi e altre proteine cellulari, la p53 mutata modifica profondamente il funzionamento della cellula tumorale, alterando sia l'insieme dei geni attivi (trascrittoma) sia quello delle proteine prodotte (proteoma), e interferendo con numerosi processi vitali.
Giannino Del Sal ha dato importanti contributi allo studio della p53. Il suo gruppo ha identificato diversi segnali che innescano la rete oncogenica della p53 mutata nei tumori e nella loro progressione. Ha scoperto nodi cruciali in questa rete e nuovi potenziali bersagli terapeutici. Inoltre, ha messo in luce meccanismi inediti che regolano la stabilità della p53 mutata all’interno del tumore, collegandoli ai cambiamenti nelle proprietà fisiche del microambiente tumorale – cioè il contesto cellulare che circonda il tumore – e alle alterazioni del metabolismo cellulare, una caratteristica chiave delle cellule tumorali.
In particolare, è stato dimostrato che la p53 mutata può riprogrammare il metabolismo della cellula tumorale, attivando la cosiddetta via del mevalonato – un processo biochimico coinvolto nella sintesi di lipidi e altre molecole essenziali. Questo meccanismo ha anche rivelato un'interazione inaspettata con le proteine YAP e TAZ, sensori cellulari che regolano la crescita e la risposta alle forze meccaniche, confermando che i percorsi oncogenici di p53 mutata e YAP/TAZ non agiscono in modo indipendente, ma si influenzano reciprocamente e cooperano nel determinare il comportamento aggressivo del tumore.
Le evidenze raccolte dal gruppo e da altri studi dimostrano che le varianti mutanti di p53 contribuiscono allo sviluppo e alla progressione di diversi tipi di tumore, favorendo la sopravvivenza delle cellule tumorali e la loro capacità di adattarsi agli stress associati alla trasformazione tumorale, come danni al DNA, ipossia (carenza di ossigeno), squilibri metabolici, stress ossidativo e stress proteotossico, ovvero l'accumulo di proteine danneggiate. In questo contesto, Del Sal ha fornito esempi emblematici di come l’attività della p53 mutata possa aprire nuove possibilità terapeutiche.
Obiettivi specifici del programma
Sebbene la rete molecolare della p53, sia nella sua forma normale che mutata, sia stata ampiamente studiata da Del Sal e da altri ricercatori, essa presenta ancora molti aspetti da chiarire. Questo non solo per il suo ruolo centrale nella biologia del cancro, ma anche perché rappresenta un modello per comprendere come una rete di segnalazione cellulare possa passare da funzione protettiva (oncosoppressiva) a dannosa (oncogenica), e come queste due modalità interagiscano nel contesto tumorale.
Su queste basi, l’Università di Trieste, dove Del Sal è professore di Biologia Applicata, e IFOM hanno creato una nuova unità di ricerca che unisce l’esperienza del ricercatore con l’ambiente scientifico altamente collaborativo di IFOM. Questo programma si propone di sviluppare ricerca innovativa su cinque principali direttrici:
- Approfondire il legame tra metabolismo tumorale e segnalazione oncogenica. Il progetto indagherà come le alterazioni metaboliche causate da p53 mutata, oltre alla via del mevalonato, contribuiscano alla progressione metastatica del tumore.
- Esplorare come i programmi oncogenici attivati da p53 mutata regolino l’interazione tra le cellule tumorali e il microambiente circostante.
- Studiare l’interazione tra segnali meccanici (mechano-signaling) e metabolismo nella funzione acquisita della p53 mutata. Si analizzerà come la p53 mutata e le proteine YAP/TAZ rispondano a stimoli meccanici e chimici nel microambiente e come ciò favorisca la diffusione metastatica.
- Indagare i meccanismi attraverso cui la p53 mutata aiuta le cellule tumorali ad adattarsi agli stress tipici del cancro.
- Identificare combinazioni di farmaci per trattare i tumori che esprimono p53 mutata. Il progetto proseguirà l'esplorazione di combinazioni farmacologiche sinergiche, puntando anche sul riutilizzo di farmaci noti (drug repositioning), come le statine, i bisfosfonati e altri inibitori del mevalonato, per destabilizzare la p53 mutata e ridurre la rigidità del tumore.
Approccio metodologico
L’unità di ricerca utilizza una vasta gamma di modelli e tecnologie all’avanguardia, come gli screening funzionali ad alta capacità (high-content/high-throughput) e approcci “omici” – ovvero analisi su larga scala di geni, proteine e metaboliti.
Per studiare l’inizio e la progressione del tumore si impiegano:
- colture cellulari 2D/3D modificate geneticamente,
- organoidi tumorali derivati da pazienti,
- modelli preclinici murini e di Drosophila melanogaster,
- xenotrapianti tumorali (tumori umani impiantati in animali da laboratorio).
L’unità ha anche accesso a archivi di tumori umani conservati in formalina e a campioni freschi congelati corredati di informazioni cliniche, in particolare da tumori della mammella e di altri tipi.
Impatto sulla ricerca sul cancro
Negli ultimi anni, il gruppo guidato da Del Sal ha fornito esempi chiave di come lo studio delle attività della p53 mutata possa rivelare vulnerabilità insospettate dei tumori, aprendo la strada a nuovi trattamenti. Il lavoro è destinato a fornire basi scientifiche solide per la progettazione di terapie più efficaci.
Photogallery
 Localization of YAP/TAZ in breast cancer cells untreated and treated with statin. (RED= YAP/TAZ; BLUE=NUCLEI) - 1/2
Localization of YAP/TAZ in breast cancer cells untreated and treated with statin. (RED= YAP/TAZ; BLUE=NUCLEI) - 1/2 Localization of YAP/TAZ in breast cancer cells untreated and treated with statin. (RED= YAP/TAZ; BLUE=NUCLEI) - 2/2
Localization of YAP/TAZ in breast cancer cells untreated and treated with statin. (RED= YAP/TAZ; BLUE=NUCLEI) - 2/2 Cancer Associated Fibroblasts (brown) (α-SMA) infiltrating a breast cancer metastasis
Cancer Associated Fibroblasts (brown) (α-SMA) infiltrating a breast cancer metastasis
 Breast cancer organoid
Breast cancer organoid  Drosophila adipocytes in the larval fat body - Lipid Droplets (green) DNA (Blues) Hoechst
Drosophila adipocytes in the larval fat body - Lipid Droplets (green) DNA (Blues) Hoechst
